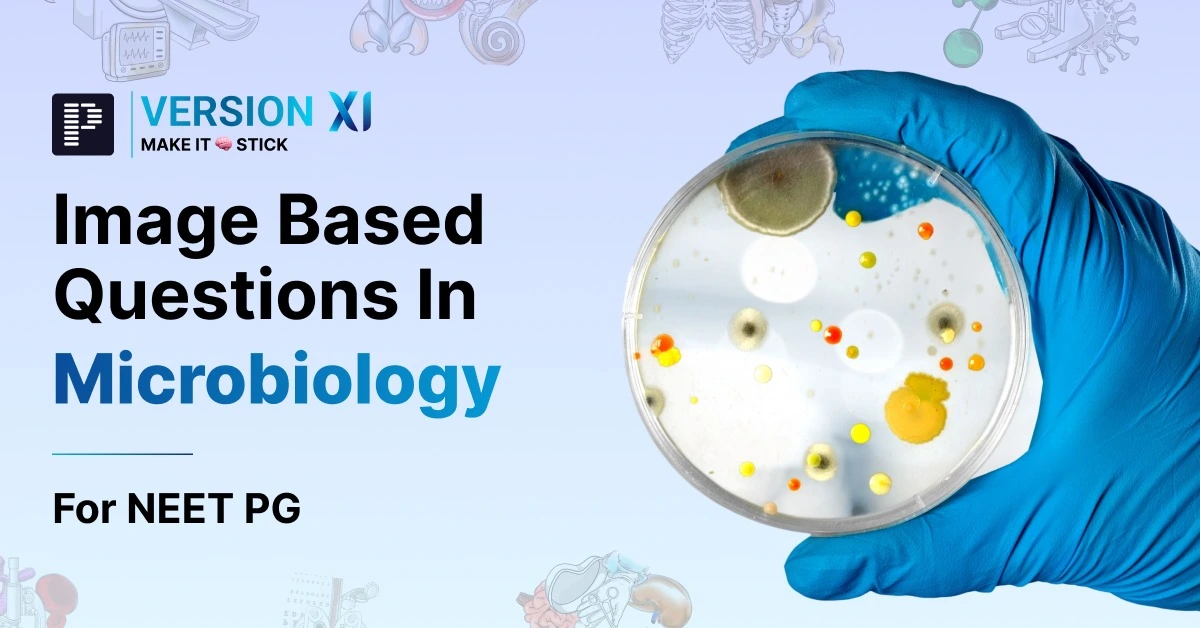

Microbiology Image Based Questions for NEET PG 2026
Mar 6, 2026
Q1. An 8-year-old boy presents with a 5-day history of severe sore throat, high fever, hoarseness of voice, and swollen neck. Physical examination reveals a thick greyish pseudomembrane in the throat and significant cervical lymphadenopathy. A throat swab was sent for microbiological analysis and revealed the following. Which staining technique is used to identify the causative organism in this case?

- Albert stain
- Gram stain
- Zeil Neelsen stain
- Gabbet stain
Ans. 1) Albert stain
Also read: Pharmacology Image Based Questions for NEET PG
Q2. Identify ‘A’ in the following image.

- Lipoteichoic acid
- O antigen
- Lipid A
- Teichoic acid
Ans. 2) O antigen
Q3. Which among the given options exhibits swarming behavior?

- Salmonella enterica
- Vibrio cholerae
- Bacillus cereus
- Proteus mirabilis
Ans. 4) Proteus mirabilis
Q4. Leifson and Ryu's stain is used for staining which of the following?

- Fungi
- Mycobacteria
- Flagella
- Capsules
Ans. 3) Flagella
Also read: Pathology Image Based Questions for NEET PG
Q5. What is the ideal agent of choice for sterilizing the shown instrument?

- 2% Glutaraldehyde
- Ethylene oxide
- 35% Hydrogen peroxide
- Isopropyl alcohol
Ans. 1) 2% Glutaraldehyde
|
|
|
|
|
|
|
|
|
|
|
|
Q6. A 6-year-old boy presents with fever, sore throat, and rash that started on the neck and chest and then spread to the trunk and extremities. Examination findings are given below. Which of the following is the most likely diagnosis?


- Kawasaki disease
- Scarlet fever
- Toxic shock syndrome
- Erysipelas
Ans. 2) Scarlet fever
Q7. A 35-year-old male presents with painless, progressive genital ulcers. A tissue biopsy is taken, and a Wright-Giemsa stain is performed. The microscopic examination reveals Donovan bodies within macrophages as shown below. What is the most likely diagnosis?

- Syphilis
- Gonorrhea
- Chlamydia
- Granuloma inguinale
Ans. 4) Granuloma inguinale
Also read: Physiology Image Based Questions for NEET PG
Q8. A hiker had recently returned from a forest expedition with complaints of high grade fever along with a painless blackish crusted lesion at the site of insect bite.The following insect was identified by him. What will a Weil-Felix test show for this patient?

- Only OX 19+
- OX 2+ and OX 19+
- OX K and OX 19+
- Only OX K+
Ans. 4) Only OX K+
Q9. Based on the image given below, which of the following statements is true regarding the symmetry of the viruses?

- Poxvirus has a symmetry similar to structure A
- Adenovirus has a symmetry similar to structure B
- Rhabdovirus has a symmetry similar to structure A
- Structure B has two types of capsomers
- The helical tube in structure A is rigid in all viruses with a similar structure.
- I, II and V
- II and IV
- II, III and IV
- I,III and V
Ans. 3) II, III and IV
Q10. Based on the steps of viral replication, label the following diagram

- A - Attachment, B - Translation, C- Transcription, D- budding
- A - Penetration, B - Translation, C- Transcription, D- budding
- A - Penetration, B - Transcription, C- Translation, D - Maturation
- A - Attachment, B - Transcription, C- Translation, D- Maturation
Ans. 3) A - Penetration, B - Transcription, C- Translation, D - Maturation
Also read: Biochemistry Image Based Questions for NEET PG
Q11. A 45-year-old patient presents with neurological symptoms, and a brain biopsy is performed, revealing the presence of inclusion bodies as shown in the image. What are these inclusion bodies commonly referred to as?

- Paschen Bodies
- Negri Bodies
- Bollinger Bodies
- Molluscum Bodies
Ans. 2) Negri Bodies
Q12. A 10-year-old child presents with hair loss and black dot tinea capitis. Microscopic examination of the hair reveals elongated hyphae within the hair shaft. Which of the following statements is true regarding the likely condition the child has?

- Trichoscopy shows perifollicular scaling
- It is commonly associated with Microsporum canis
- It typically involves Trichophyton tonsurans and Trichophyton violaceum
- The treatment of choice is typically 2 weeks
Ans. 3) It typically involves Trichophyton tonsurans and Trichophyton violaceum.
Also read: Pharmacology Important Topics For NEET PG
Q13. A 45-year-old male agricultural worker from a rural area presents with an extensive slowly growing, warty, nodular lesion on his lower leg as shown in the image below. The lesion is dark, and rough, and resembles the surface of cauliflower. He recalls injuring his leg on a thorn while working barefoot in the fields several months ago. A KOH mount of the skin specimen is shown below. What is the most likely diagnosis?

- Rhinosporidiosis
- Chromoblastomycosis
- Mycotic Mycetoma
- Sporotrichosis
Ans. 2) Chromoblastomycosis
Q14. A 40-year-old male from North America presents with cough, fever, and weight loss. Chest imaging shows focal consolidation in the lungs, and he has developed ulcerative skin lesions on his face as shown below. A skin biopsy is performed, and the sample is sent for GMS staining. An image of the GMS stain is shown below. Which of the following is the most likely diagnosis?

- Blastomycosis
- Chromoblastomycosis
- Mycotic Mycetoma
- Sporotrichosis
Ans. 1) Blastomycosis
Q15. A male patient comes with complaints of rashes on the skin that appear as follows.

He gives a history of walking barefoot in soil in the fields near his house. Which organism could be the most probable cause of this condition?
- Gnathostoma spinigerum
- Ascaris suum
- Ancylostoma braziliense
- Toxocara canis
Ans. 3) Ancylostoma braziliense
Also read: Forensic Medicine & Toxicology Important Topics For NEET PG
If you wish to access the detailed explanations for the correct and incorrect options of Image-Based Microbiology Questions for NEET PG 2026
Download the PrepLadder app now and unlock a 24-hour FREE trial of premium high-yield content. Access Smarter Video Lectures also in हिंglish, Game Changing Qbank, Audio QBank, Structured Notes, Treasures, Mock test for FREE to ace your NEET PG preparation. Elevate your study experience and gear up for success. Start your journey with PrepLadder today!

PrepLadder Medical
Get access to all the essential resources required to ace your medical exam Preparation. Stay updated with the latest news and developments in the medical exam, improve your Medical Exam preparation, and turn your dreams into a reality!
Top searching words
The most popular search terms used by aspirants
- NEET PG Microbiology
- NEET PG Microbiology Preparation
PrepLadder Version X for NEET PG
Avail 24-Hr Free Trial